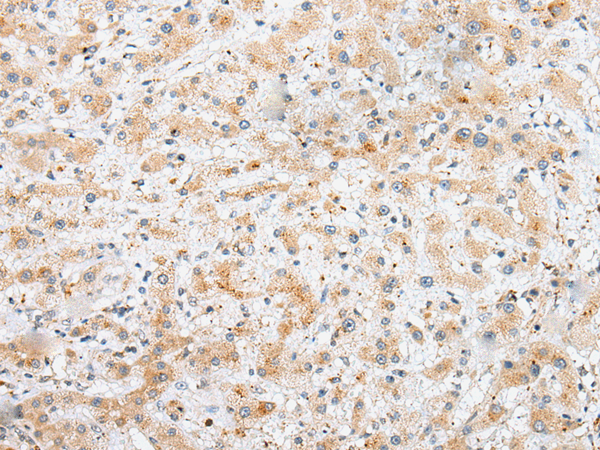
一抗

|
Background: |
Major component of the transverse central element of synaptonemal complexes (SCS), formed between homologous chromosomes during meiotic prophase. Required for chromosome loading of the central element-specific SCS proteins, and for initiating synapsis between homologous chromosomes. Chromosome loading appears to require SYCP1. Required for fertility (By similarity). |
|
Applications: |
ELISA, IHC |
|
Name of antibody: |
SYCE3 |
|
Immunogen: |
Full length fusion protein |
|
Full name: |
synaptonemal complex central element protein 3 |
|
Synonyms: |
THEG2; C22orf41 |
|
SwissProt: |
A1L190 |
|
ELISA Recommended dilution: |
5000-10000 |
|
IHC positive control: |
Human liver cancer and Human esophagus cancer |
|
IHC Recommend dilution: |
25-100 |

 購(gòu)物車
購(gòu)物車 幫助
幫助
 021-54845833/15800441009
021-54845833/15800441009